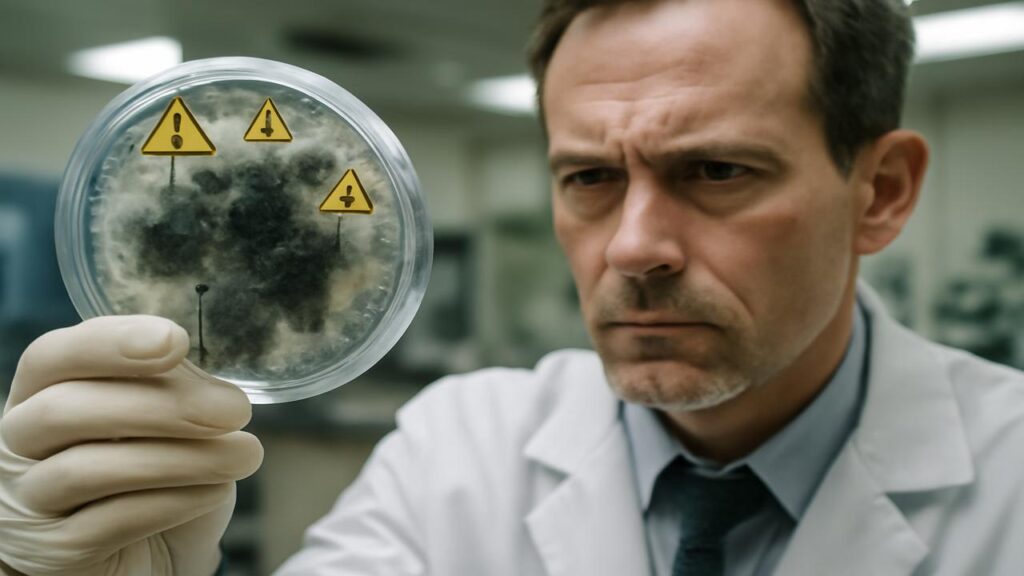

Der Geruch ist das Erste, was du wahrnimmst. Feucht, dumpf, leicht süßlich – wie ein nasser Keller, der nie richtig trocknet. Du stehst in einer Wohnung im Erdgeschoss eines alten Mietshauses, irgendwo in einer europäischen Großstadt. An der Wand hinter dem Schlafzimmerschrank schimmert es dunkelgrün bis schwarz, zackig wie eine Landkarte, die sich unaufhaltsam ausbreitet. Die Bewohnerin, eine junge Mutter, erzählt mit müder Stimme von ihrem Husten, von den entzündeten Augen ihres Sohnes, von den ständigen Kopfschmerzen. Die Tapete blättert, der Putz bröckelt – und in den feinen Rissen wächst etwas, das man mit bloßem Auge kaum versteht: ein gefährliches, oft unsichtbares Netzwerk aus Pilzfäden, Sporen und Giftstoffen.
Wenn der Gegner unsichtbar ist
Schimmel ist nichts Neues. Seit es Häuser gibt, wächst er in ihren feuchten Ecken. Seit es Lebensmittel gibt, verdirbt er unser Brot, unsere Früchte, unsere Vorräte. Doch Ärztinnen, Mikrobiologen und Epidemiologen beginnen, über Schimmel auf eine neue Weise zu sprechen. Nicht mehr nur als lästiges Wohnproblem, sondern als globale Gesundheitsgefahr. Denn einige Pilze – darunter Arten, die in feuchten Wänden, in Böden oder sogar in Krankenhäusern lauern – werden tödlicher, widerstandsfähiger, unberechenbarer.
Der unsichtbare Gegner ist nicht laut. Er schreit nicht, er klirrt nicht, er macht keinen Alarm. Er reist leise – in Luftströmen, an Schuhsohlen, in Klimaanlagen, in Krankenhausfluren. Ein Mensch mit geschwächtem Immunsystem atmet die Sporen ein, vielleicht nach einer Chemotherapie, vielleicht nach einer schweren Virusinfektion. Erst ist es nur ein leichter Husten, ein Kratzen im Hals, ein bisschen Fieber. Dann, manchmal zu spät, erkennt man: Es ist ein Pilz, der längst im Körper Wurzeln geschlagen hat.
Der Aufstieg der Killerpilze
In Kliniken auf der ganzen Welt häufen sich die Berichte: Patienten, die alle verfügbaren Medikamente bekommen – und trotzdem an einer Pilzinfektion sterben. Ärztinnen beschreiben es als Gefühl der Ohnmacht. Sie kennen Bakterien, sie fürchten multiresistente Keime. Doch Pilze? Die waren lange Nebenfiguren in der großen Geschichte der Infektionskrankheiten. Jetzt treten sie nach vorn.
Einige Arten haben es bereits zu trauriger Berühmtheit gebracht. Aspergillus, ein Schimmelpilz, der in Erde, Kompost, Hausstaub und auf Lebensmitteln vorkommt, kann bei Menschen mit schwacher Abwehr eine lebensbedrohliche Lungeninfektion auslösen. Candida auris, ein Hefepilz, nistet sich in Krankenhäusern ein, überlebt auf Oberflächen und ist oft resistent gegen mehrere Wirkstoffklassen. Und in tropischen Regionen kämpfen Ärztinnen gegen Pilzerkrankungen, die ganze Organe zerstören – langsam, hartnäckig, schwer behandelbar.
Was diese Erreger so beunruhigend macht, ist ihre Anpassungsfähigkeit. Pilze sind Überlebenskünstler. Sie existieren seit hunderten Millionen Jahren, haben Klimakatastrophen überstanden, neue Lebensräume erobert, sich an Hitze, Kälte, Trockenheit und Feuchtigkeit angepasst. Jetzt, in einer Zeit, in der der Planet sich rasant verändert, spielen sie diese Evolutionserfahrung aus. Höhere Durchschnittstemperaturen, veränderte Niederschlagsmuster, Extremwetter – all das schafft neue Nischen für Pilzarten, die bisher begrenzt waren. Manche von ihnen lernen, bei höherer Temperatur zu wachsen – und dringen damit in den menschlichen Körper vor, dessen 37 Grad lange als natürliche Barriere galten.
Klima, Städte, Körper: Ein perfekter Sturm
Stell dir einen heißen Sommer in der Stadt vor. Die Luft steht, Beton speichert die Wärme, Klimaanlagen laufen auf Hochtouren. In schlecht gewarteten Anlagen können sich Pilze in feuchten Filtern ansiedeln, unbemerkt mit der Raumluft verteilt. In überfluteten Kellern nach Starkregen quillt Dämmmaterial auf, Wände trocknen nur oberflächlich – dahinter wächst, gut versteckt, ein dichter Teppich aus Sporen.
Parallel dazu steigen weltweit die Zahlen chronisch kranker Menschen: Diabetes, Krebserkrankungen, Autoimmunleiden. Mehr Menschen brauchen Immunsuppressiva, mehr Menschen durchlaufen aggressive Therapien. Ihre Abwehr ist geschwächt – genau die Lücke, durch die opportunistische Pilze schlüpfen. Ein nasser Keller ist dann nicht mehr nur ein Ärgernis, sondern ein potenzielles Risiko. Ein verschimmelter Luftbefeuchter, eine alte Matratze, eine schimmelige Lüftung können zur Quelle einer Infektion werden, die sich still im Körper ausbreitet.
Auch unsere globalisierte Lebensweise spielt mit. Obst, Gemüse, Getreide, Holz, Pflanzen – sie reisen in Containern um den Planeten. Mit ihnen reisen Pilzsporen, die sich in neuen Regionen ansiedeln, lokale Arten verdrängen oder mit ihnen konkurrieren. Was gestern noch ein regionales Problem war, kann morgen ein globales werden.
Wenn Schimmel tödlich wird
Schimmel in der Wohnung ist nicht gleich Killerpilz. Doch die Grenzen sind fließender, als viele denken. Einige Schimmelpilze in Innenräumen produzieren Mykotoxine – Giftstoffe, die die Atemwege reizen, Entzündungen fördern und bei hoher Belastung Organe schädigen können. Für gesunde Menschen bedeutet das oft „nur“ Kopfschmerzen, Schlafstörungen, Atemprobleme. Für Menschen mit Asthma, chronischer Bronchitis oder geschwächtem Immunsystem kann sich dieser Cocktail jedoch gefährlich zuspitzen.
In Kliniken sehen Ärztinnen vermehrt schwere Pilzinfektionen der Lunge, des Blutes, des Gehirns. Die Symptome sind tückisch unspezifisch: Fieber, Müdigkeit, ungewöhnliche Schmerzen, Sehstörungen, hartnäckiger Husten. Nicht selten wird zuerst an bakterielle Infektionen gedacht, Antibiotika werden verordnet – doch sie helfen nicht. Währenddessen kann ein invasiver Pilz weiterwachsen, Blutgefäße befallen, Gewebe zerstören.
Dazu kommt ein Problem, das wir aus der Welt der Bakterien bereits kennen: Resistenzen. Antimykotika – Medikamente gegen Pilze – sind zwar vorhanden, aber es gibt weit weniger Wirkstoffklassen als bei Antibiotika. Und ein Teil dieser Wirkstoffe wird auch in der Landwirtschaft eingesetzt, um Pflanzen vor Pilzbefall zu schützen. Pilze, die dort Resistenzen entwickeln, können später im menschlichen Körper praktisch unverwundbar sein. Was auf einem Feld beginnt, kann im Krankenhaus enden.
Wie Schimmel unseren Alltag erreicht
Die globale Pilz-Gefahr klingt abstrakt – bis du beginnst, sie in deinem Alltag zu sehen. Im Badezimmer, wo der Putz um die Duschkabine dunkler wird. In der Küche, wo eine vergessene Orange mit einem pelzigen Pelz überzogen ist. Im alten Bücherkarton auf dem Dachboden, wo es muffig riecht und die Seiten fleckig werden.
Doch nicht jedes Fleckchen ist gleich alarmierend, und Panik hilft niemandem. Was hilft, ist ein bewusster Blick. Woher kommt die Feuchtigkeit? Ist es nur oberflächlicher Kondensschimmel an einer kalten Außenwand – oder ein Hinweis auf ein tieferes Problem wie einen Rohrbruch, aufsteigende Feuchtigkeit, fehlende Dämmung? Und vor allem: Wer lebt im Haus? Sind dort Menschen mit geschwächtem Immunsystem, kleine Kinder, ältere Personen, Asthmatiker?
| Situation | Mögliches Risiko | Empfohlene Reaktion |
|---|---|---|
| Kleine Schimmelflecken im Bad (unter 0,5 m²) | Lokal begrenzt, meist geringes Risiko für Gesunde | Gut lüften, Fleck fachgerecht entfernen, Ursache (Feuchte) reduzieren |
| Großflächiger Befall an Wänden, muffiger Geruch | Erhöhte Sporenbelastung, problematisch für empfindliche Personen | Fachgutachten einholen, Sanierung planen, ggf. zeitweise Auszug prüfen |
| Schimmel bei Menschen mit Immunschwäche | Ernsthaftes Gesundheitsrisiko, mögliches Einfallstor für Infektionen | Ärztlichen Rat einholen, rasche und professionelle Schimmelbeseitigung |
| Verschimmeltes Essen im Kühlschrank | Mykotoxine möglich, besonders bei Nüssen, Getreide, Obst | Großzügig entsorgen, Oberflächen reinigen, Vorratshaltung prüfen |
| Feuchte Keller, nasser Geruch, dunkle Ecken | Langfristige Belastung, Sporen verteilen sich ins Haus | Ursache der Feuchte klären, abdichten, lüften, ggf. Trocknung veranlassen |
In all diesen Situationen verschwimmt die Grenze zwischen dem, was wir mit den Augen sehen können, und dem, was im Mikrokosmos passiert. Ein unscheinbarer schwarzer Punkt an der Silikonfuge mag harmlos aussehen, gehört aber zu einem System, das Sporen freisetzt, sich über Luftströme verbreitet, Oberflächen kolonisiert. Den Pilzen ist egal, ob wir sie „Wohnungsschimmel“ oder „krankmachenden Erreger“ nennen. Sie tun, was sie seit Millionen Jahren tun: wachsen, wenn die Bedingungen stimmen.
Was Ärztinnen heute anders machen müssen
In vielen Praxen beginnt ein Umdenken. Wenn eine Patientin mit unerklärlichem Fieber, anhaltendem Husten und diffuser Schwäche auftaucht, steht heute häufiger der Gedanke im Raum: Könnte es ein Pilz sein? Statt nur Antibiotika zu verschreiben, werden spezielle Labortests veranlasst, Bildgebung der Lunge, manchmal Gewebeproben. Besonders bei Menschen mit Vorerkrankungen gehen Ärzte wachsamer vor.
Zur gleichen Zeit wächst in Krankenhäusern die Erkenntnis, dass Infektionsschutz nicht nur bedeutet, Bakterien zu bekämpfen. Pilzsporen können in staubigen Gebäudeteilen lauern, in wasserführenden Systemen, in schlecht gewarteten Klimaanlagen. Baumaßnahmen in Klinikgebäuden können plötzlich lebensbedrohlich werden, wenn Staub mit Aspergillus-Sporen in Intensivstationen gelangt. Deswegen planen viele Häuser heute Sanierungen anders, mit speziellen Filtern, Unterdrucksystemen, strengeren Protokollen.
Und dann ist da noch die Forschung: Labore auf der ganzen Welt versuchen zu verstehen, wie Pilze Resistenzen entwickeln, welche genetischen Tricks sie nutzen, um sich dem menschlichen Immunsystem zu entziehen. Neue Medikamente werden getestet, neue Diagnostikverfahren entwickelt, die schneller und präziser anzeigen, ob ein gefährlicher Pilz im Körper aktiv ist. Die Zeit ist ein entscheidender Faktor: Je früher eine Pilzinfektion erkannt wird, desto besser sind die Chancen, sie in den Griff zu bekommen.
Was wir selbst tun können, bevor es ernst wird
Die globale Pilz-Gefahr klingt nach einem Problem, das vor allem Wissenschaftler, Politiker und Klinikleitungen beschäftigen sollte. Doch ein Teil der Antwort liegt in unseren Händen – in unseren Wohnungen, in unserem Alltag, in unseren Entscheidungen.
Zuerst: Feuchtigkeit ist der stärkste Verbündete des Schimmels. Regelmäßiges, bewusstes Lüften – Stoßlüften statt dauerhaft gekippter Fenster – hilft, die Luftfeuchtigkeit zu senken. Im Winter sollte Wäsche möglichst nicht in der Wohnung getrocknet werden, oder nur mit guter Lüftung. Möbel an Außenwänden sollten nicht direkt anliegen, damit Luft zirkulieren kann. Kondenswasser an Fenstern ist ein Warnsignal: Es zeigt, dass Luftfeuchtigkeit und Oberflächentemperatur aus dem Gleichgewicht geraten sind.
Dann: Hinschauen. Hinter Schränken, unter Teppichen, in Ecken, in denen es muffig riecht. Ein einfacher erster Anhaltspunkt ist der Geruch. Wenn ein Raum dauerhaft modrig riecht, stimmt etwas nicht – auch dann, wenn man noch keinen sichtbaren Schimmel findet. In Mietwohnungen lohnt es sich, früh mit Vermietenden zu sprechen, bevor ein kleines Problem zu einem großen Bauschaden wird.
Bei Lebensmitteln gilt: Vorsicht statt Wegschneiden. Viele Schimmelarten auf Brot, Nüssen oder Obst bilden Giftstoffe, die sich unsichtbar im Lebensmittel ausbreiten. Ein schimmliger Rand bedeutet nicht, dass der Rest sicher ist. Besonders empfindlich sind Nüsse, Getreideprodukte und Trockenfrüchte. Hier hilft eine kühle, trockene Lagerung – und im Zweifel ein beherzter Griff zum Mülleimer.
Zwischen Gelassenheit und Wachsamkeit
Die größte Herausforderung im Umgang mit Schimmel ist oft psychologischer Natur: die Balance zwischen Panik und Verdrängung. Wer bei jedem kleinen Fleckchen in der Dusche von „tödlichem Pilz“ spricht, verfehlt die Realität genauso wie jemand, der wochenlang in einem stockigen Zimmer schläft und die Symptome als „Erkältung“ abtut.
Für gesunde Menschen bedeutet Schimmel in der Regel vor allem eines: ein Warnzeichen dafür, dass die Bausubstanz oder das Wohnklima nicht stimmt. Für empfindliche Menschen – dazu gehören auch Kinder, ältere Menschen, Schwangere und alle mit Atemwegserkrankungen – kann dieselbe Situation aber schon deutlich mehr Belastung bedeuten. Und für schwer immungeschwächte Personen gilt: Schimmel gehört schlicht nicht zum akzeptablen Hintergrundrauschen ihres Lebens.
Vielleicht ist es hilfreich, Pilze als das zu sehen, was sie biologisch sind: geniale Recycler, die abgestorbenes Material zersetzen, Stoffkreisläufe schließen, Wälder gesund halten. Ohne Pilze gäbe es keine fruchtbaren Böden, keinen Waldduft nach Regen, kein Brot, keinen Wein, kein Bier, keine Hefe im Teig. Sie sind unverzichtbare Partner in den Ökosystemen dieses Planeten. Das Problem entsteht, wenn sie in Räume eindringen, in denen wir verletzlich sind – in unsere Lungen, unsere Blutbahnen, unsere schlecht belüfteten Zimmer.
Die leise Lektion der Sporen
Am Ende dieses Bogens – von der feuchten Wand in der Erdgeschosswohnung bis zur Intensivstation, in der Ärztinnen gegen invasive Pilzinfektionen kämpfen – steht eine leise, aber eindringliche Lektion. Sie erzählt von einem Teil der Natur, den wir lange unterschätzt haben. Bakterien, Viren, Parasiten – sie alle waren im Fokus, während die Pilze im Schatten blieben, still, langsam, unauffällig.
Jetzt treten sie hervor. Nicht als plötzliche, apokalyptische Bedrohung, sondern als stetig wachsende Herausforderung in einer Welt, die wärmer, dichter besiedelt, verletzlicher wird. Die Warnung der Ärztinnen und Ärzte vor der globalen Pilz-Gefahr ist keine Einladung zur Angst, sondern zur Aufmerksamkeit. Sie fordert uns auf, genauer hinzuschauen – auf die Flecken an unseren Wänden, auf die Menschen, die besonders geschützt werden müssen, auf die Art, wie wir bauen, wirtschaften, Landwirtschaft betreiben.
Als du die Wohnung der jungen Mutter wieder verlässt, fällt das Licht der Nachmittagssonne durch das Treppenhausfenster. Der Geruch aus der Wohnung haftet noch kurz in deiner Kleidung, bevor er im Straßenlärm untergeht. Draußen fahren Fahrräder vorbei, Kinder lachen, Menschen tragen Einkaufstüten nach Hause. Alles wirkt normal, alltäglich. Doch irgendwo in den Ritzen der Gehwegplatten, in den Fugen eines feuchten Kellers, auf der Schale einer überreifen Frucht wachsen leise die Sporen weiter.
Die Frage ist nicht, ob wir Pilze vollständig besiegen können – das werden wir nicht. Die Frage ist, ob wir sie ernst genug nehmen, um mit ihnen zu leben, ohne uns von ihnen beherrschen zu lassen. Ob wir zuhören, wenn Ärztinnen sagen: Achtet auf die feuchten Ecken. Unterschätzt die leiseren Gefahren nicht. Denn manche der bedrohlichsten Gegner kommen nicht mit Getöse – sondern als feiner Staub in der Luft, den wir kaum bemerken, während wir einatmen.
Häufige Fragen (FAQ)
Ist jeder Schimmel in der Wohnung sofort gefährlich?
Nein. Kleine, oberflächliche Flecken sind für gesunde Menschen meist kein akutes Gesundheitsdrama, aber sie sind immer ein Warnsignal für zu viel Feuchtigkeit. Je größer und dichter der Befall, desto höher die Sporenbelastung und damit das potenzielle Risiko – vor allem für empfindliche Personen.
Woran erkenne ich, dass Schimmel mir gesundheitlich schadet?
Typische Hinweise sind anhaltender Husten, gereizte Augen, Kopfschmerzen, Müdigkeit, Reizungen von Haut und Schleimhäuten – vor allem, wenn sich die Beschwerden in bestimmten Räumen verstärken und außerhalb nachlassen. Eine ärztliche Abklärung ist sinnvoll, besonders bei Vorerkrankungen.
Kann man verschimmeltes Essen einfach großzügig abschneiden?
Bei vielen Lebensmitteln ist das keine gute Idee. Mykotoxine können sich unsichtbar im ganzen Produkt verteilen. Besonders bei Brot, Nüssen, Getreide und weichen Lebensmitteln sollte das gesamte Produkt entsorgt werden. Hartkäse ist ein Sonderfall, hier kann in Einzelfällen großzügiges Wegschneiden ausreichend sein.
Wie schütze ich immungeschwächte Personen vor Schimmel?
Wichtig sind trockene, gut belüftete Wohnräume ohne sichtbaren Schimmelbefall, regelmäßige Reinigung, kein Lagern in feuchten Kellern und ein kritischer Blick auf Luftbefeuchter oder Zimmerpflanzen in schlecht gelüfteten Räumen. Bei jedem sichtbaren Befall sollte zügig fachkundig saniert werden.
Warum sprechen Ärztinnen heute von einer „globalen Pilz-Gefahr“?
Weil sich mehrere Entwicklungen überlagern: mehr immungeschwächte Menschen, ein sich erwärmendes Klima, globale Handelswege und zunehmende Resistenzen gegen Antipilz-Medikamente. Zusammen führen sie dazu, dass gefährliche Pilzinfektionen häufiger, schwerer behandelbar und geografisch weiter verbreitet werden.
Hilft es, prophylaktisch Antimykotika einzunehmen?
Nein. Eine vorbeugende Einnahme ohne medizinische Indikation ist nicht sinnvoll und kann Resistenzen fördern. Antimykotika sollten nur unter ärztlicher Kontrolle und bei klarer Diagnose eingesetzt werden.
Was kann ich sofort tun, wenn ich größeren Schimmelbefall entdecke?
Ruhe bewahren, die Ursache der Feuchtigkeit suchen, betroffene Räume gut lüften und, wenn gesundheitliche Risiken bestehen oder der Befall groß ist, fachlichen Rat einholen. Provisorische Eigenmaßnahmen sollten niemals eine gründliche Sanierung ersetzen, wenn die Substanz tiefer betroffen ist.